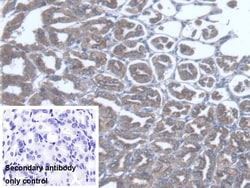
Invitrogen TST Polyclonal Antibody 20 &mu;L; Unconjugated:Antibodies, Polyclonal

Promotional price valid on web orders only. Your contract pricing may differ. Interested in signing up for a dedicated account number?
Learn More
Learn More
Invitrogen™ TST Polyclonal Antibody
Rabbit Polyclonal Antibody
Supplier: Invitrogen™ PA5121520
This item is not returnable.
View return policy
Description
TST Polyclonal Antibody for Western Blot, IHC (P)
The product of this gene is a mitochondrial matrix enzyme that is encoded by the nucleus. It may play roles in cyanide detoxification, the formation of iron-sulfur proteins, and the modification of sulfur-containing enzymes. The gene product contains two highly conservative domains (rhodanese homology domains), suggesting these domains have a common evolutionary origin.
Specifications
| TST | |
| Polyclonal | |
| Unconjugated | |
| TST | |
| LL22NC01-146D10.3; MGC19578; RDS; RHODAN; Rhodanese; thiosulfate sulfurtransferase; thiosulfate sulfurtransferase (rhodanese); thiosulfate sulfurtransferase, mitochondrial; Thiosulfate sulphurtransferase (rhodanese); TST | |
| Rabbit | |
| Antigen affinity chromatography, Protein A | |
| RUO | |
| 22117, 7263 | |
| Store at 4°C short term. For long term storage, store at -20°C, avoiding freeze/thaw cycles. | |
| Liquid |
| Immunohistochemistry (Paraffin), Western Blot | |
| 0.5 mg/mL | |
| PBS with 50% glycerol and 0.05% ProClin 300; pH 7.4 | |
| P52196, Q16762 | |
| TST | |
| Recombinant protein Thiosulfate Sulfurtransferase. The antigen corresponds to amino acid range 2-297 of the target protein. | |
| 20 μL | |
| Primary | |
| Human, Mouse | |
| Antibody | |
| IgG |
Product Content Correction
Your input is important to us. Please complete this form to provide feedback related to the content on this product.
Product Title
Spot an opportunity for improvement?Share a Content Correction